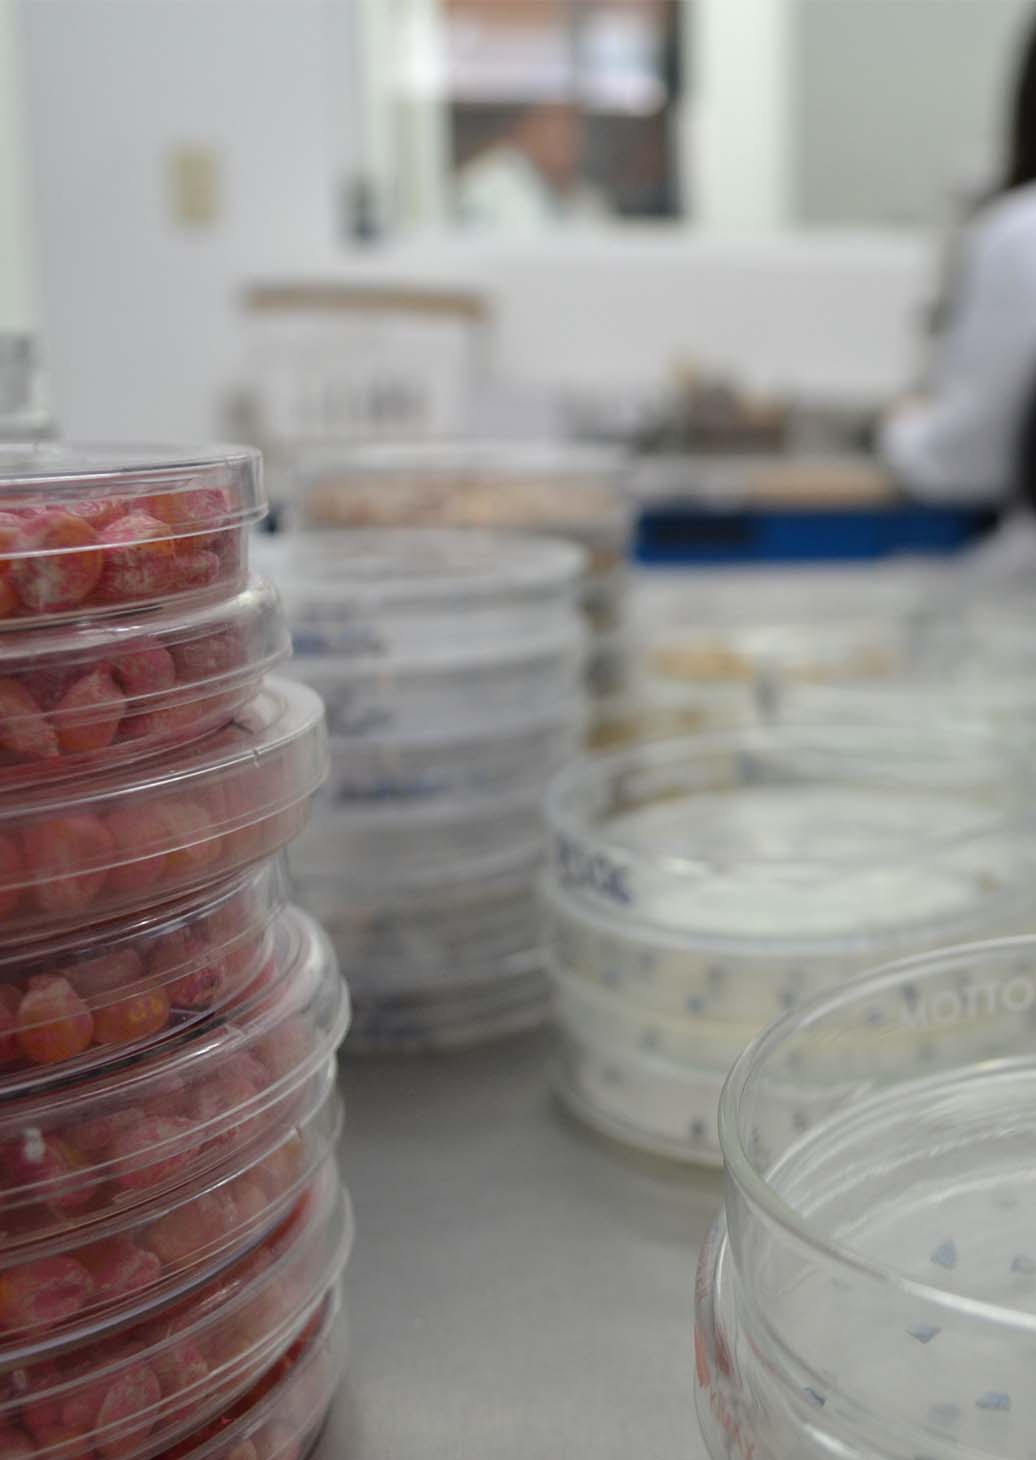

Somos el laboratorio que se encargar de cumplir tus requerimientos y facilitar tus operaciones
La calidad y eficiencia nos define
En la estratégica región fronteriza de Mexicali, nuestro laboratorio nace para brindar soluciones ágiles y precisas en diagnóstico fitosanitario, atendiendo las necesidades de productores, exportadores e importadores. Contamos con tecnología de vanguardia y un equipo especializado en los cultivos clave de la zona, ofreciendo resultados confiables. Nuestra ubicación privilegiada permite responder con rapidez a los desafíos locales, evitando los costosos traslados de muestras a otros estados y garantizando una atención oportuna.
Nos diferenciamos por nuestro profundo conocimiento de los problemas y las condiciones agrícolas únicas de la región. Coadyuvamos con las instituciones de gobierno para el manejo de plagas, enfermedades y otros retos comunes en el noroeste de México.
Como aliados estratégicos del sector agrícola, combinamos ciencia aplicada con un servicio ágil para proteger la productividad y competitividad de nuestros clientes. Nuestro enfoque integrado abarca desde diagnósticos moleculares hasta recomendaciones prácticas para el campo, siempre con el objetivo de facilitar el movimiento seguro de productos agrícolas. En un mercado global cada vez más exigente, ofrecemos la combinación perfecta de conocimiento local, tecnología avanzada y soluciones a la medida de cada operación.
Diagnosticos sin fronteras para cultivos sin límites
Conoce nuestros propósitos de operación y asegura tu resultados.
Nos comprometemos a generar resultados analíticos confiables, precisos y oportunos mediante la implementación de metodologías y personal altamente capacitado. Operamos con estrictos principios de imparcialidad, integridad y confidencialidad, asegurando la eficiencia de todos nuestros procesos., manteniendo un sistema de gestión de calidad que cumpla con los más altos estándares técnicos y normativos, impulsando la mejora continua en nuestros servicios, manteniendo un enfoque centrando en entender y resolver las necesidades específicas de cada cliente, contribuyendo así a la sanidad vegetal nacional e internacional.
Brindar resultados analíticos confiables y oportunos en diagnóstico fitosanitario mediante tecnología avanzada y personal especializado, garantizando la calidad técnica y cumplimiento normativo para fortalecer la seguridad agroalimentaria nacional y facilitar el comercio internacional.
Ser reconocidos como referentes en análisis fitosanitarios por nuestra excelencia técnica, innovación metodológica y capacidad de adaptación a los retos globales de la agricultura, estableciéndonos como socios estratégicos en la cadena agrocomercializadora.
Socios comerciales
Contacta con nosotros y descubre los beneficios de formar parte de nuestra cobertura nacional.